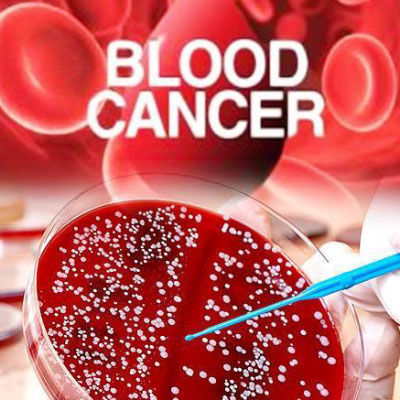
blood cancer treatment

What is Blood Cancer?
Blood cancer takes place when some thing goes incorrect with the improvement of your blood cells. This type of cancer starts offevolved in bone marrow that's the quintessential source of blood manufacturing. This stops them working properly and they may grow out of control. It may forestall your blood doing the things usually and does now not maintain you wholesome, like combating off infections or helping repair your body. The blood manufacturing procedure is interrupted due to the growth of an abnormal type of blood mobile. Dr. CS. Ranjit Kumar MBBS, DNB (Gold Medal), DM (JIPMER) is doing best treatment for blood cancer in Hyderabad, India. He is well experienced doctors in cancer treatments. He has finished MBBS between 2001-2007 S.V. Medical College, Tirupathi, NTRUHS, India he is a specialised doctor for blood cancers.

Types of Blood cancers
Blood cancer is of three types:
Leukaemia -
This type of cancers is due to the speedy production of bizarre blood cells within the bone marrow. These abnormal blood cells affect the bone marrow's potential of the manufacturing of pink blood cells and platelets. Bone Marrow Transplant Treatment may also makes use of for a few blood cancer cases, this treatment process is a way of giving very excessive dose chemotherapy, every so often with complete body radiotherapy. Bone marrow is a spongy material that fills the bones. Dr. CS Ranjit is specialised in Marrow Transplant Treatment in Gachibowli, Hyderabad, India.
Lymphoma -
This sort of blood cancer influences the lymphatic machine, that's accountable for the removal of extra fluids out of your body and generating immune cells. Lymphocytes are a sort of white blood cellular that fights infection. Abnormal lymphocytes turn out to be lymphoma cells, which develop uncontrollably for your lymph nodes and other tissues.
Myeloma -
This type of blood cancer affects the plasma cells, which are white blood cells chargeable for the manufacturing of disease-fighting antibodies in the frame. Myeloma affects the manufacturing of plasma cells which ends up in weak immune system.
Stages in Blood Cancer?
Signs And Symptoms Of Blood Cancer
Blood cancer is a type of malignancy which affects the blood, bone marrow, or lymphatic system. Some of the common blood cancer symptoms include:
- Fever
- Lymph node Swelling
- Bruising
- Bleeding at any Site | Skin Bleeds
- Weakness
- Fatigue
- Shortness of breath
Some late blood cancer symptoms are like:
- Bluish coloration of the lips or nail fingers
- change in mental status or sudden behaviour change such as confusion, lethargy
- change in the level of alertness such as unresponsiveness
- chest pain, chest tightness, chest pressure.
- high fever
- Rapid heart rate
- Respiratory or breathing problems such as breath, difficulty in breathing, wheezing
Advanced Treatments of Blood Cancer
Treatment of blood cancers depends on the form of blood cancers, age, severity and plenty of other factors. We will get to know blood cancers region on your brain with our cancer screening check system, our senior most blood cancers expert Dr. CS Ranjit Kumar will do splendid myelodysplastic syndrome blood cancers remedy from Hyderabad, India earlier than going to treatment we do blood cancers genetic trying out and counselling to make affected person consciousness on cancer. The number one goal of blood cancers treatment is the complete eradication of blood cancers. Some of the commonplace remedies are
Stem Cell Transplantation
Stem cells are collected from the bone marrow, umbilical cord, and peripheral blood. They inculcate healthy blood-forming stem cells.
Chemotherapy
It is a treatment that involves drugs which are mainly given to destroy the cancer cells.
Children Cancer Doctor in Vijayawada